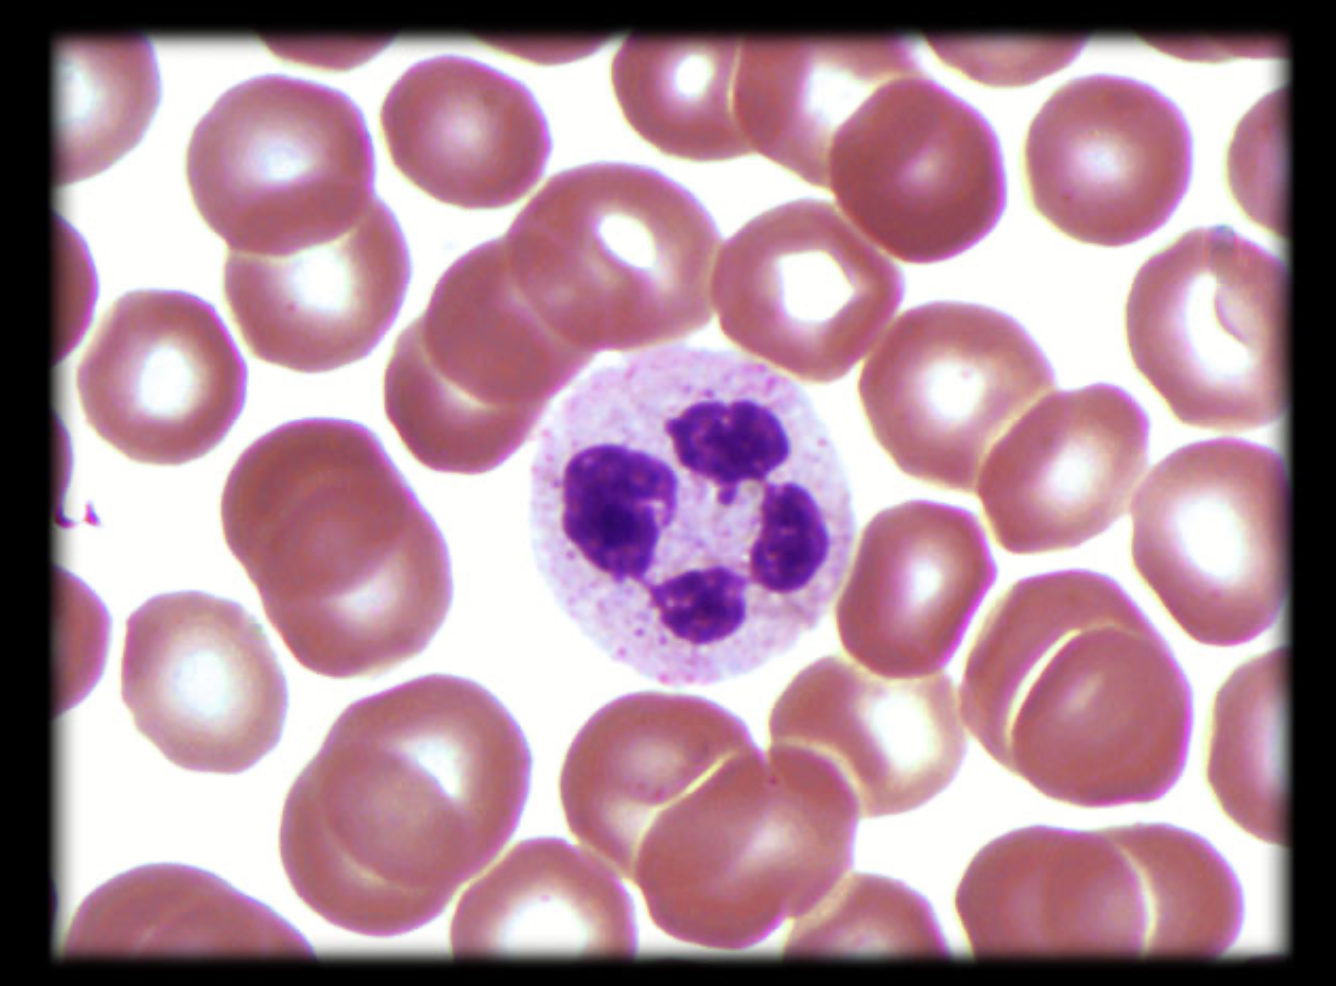
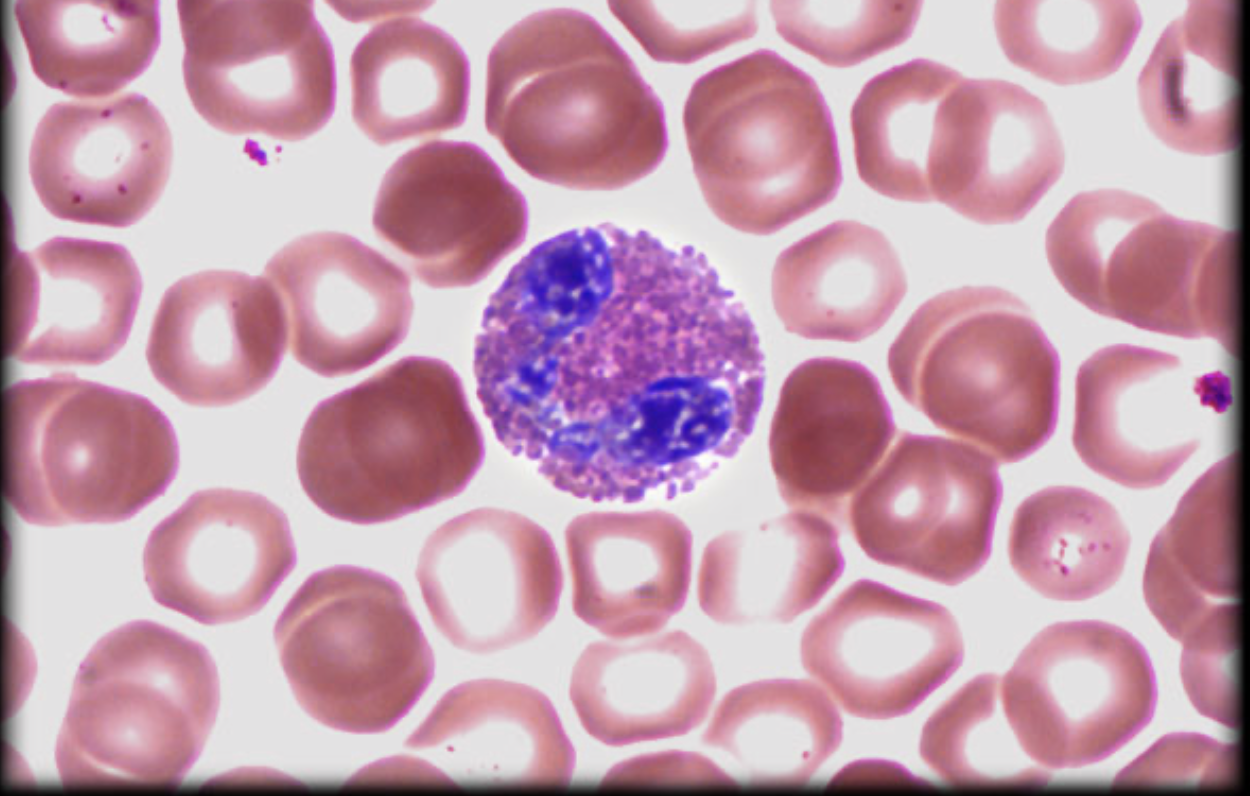
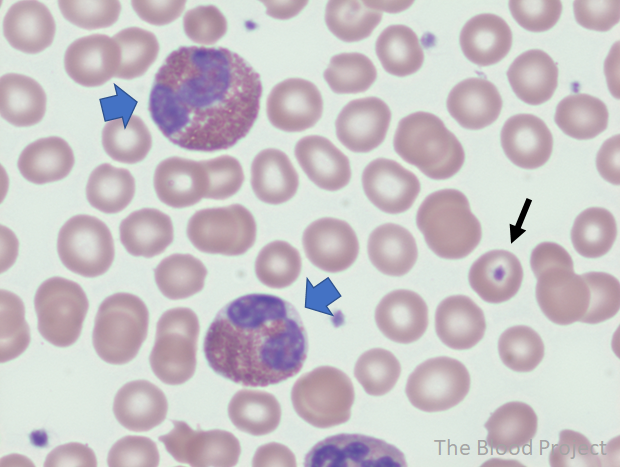
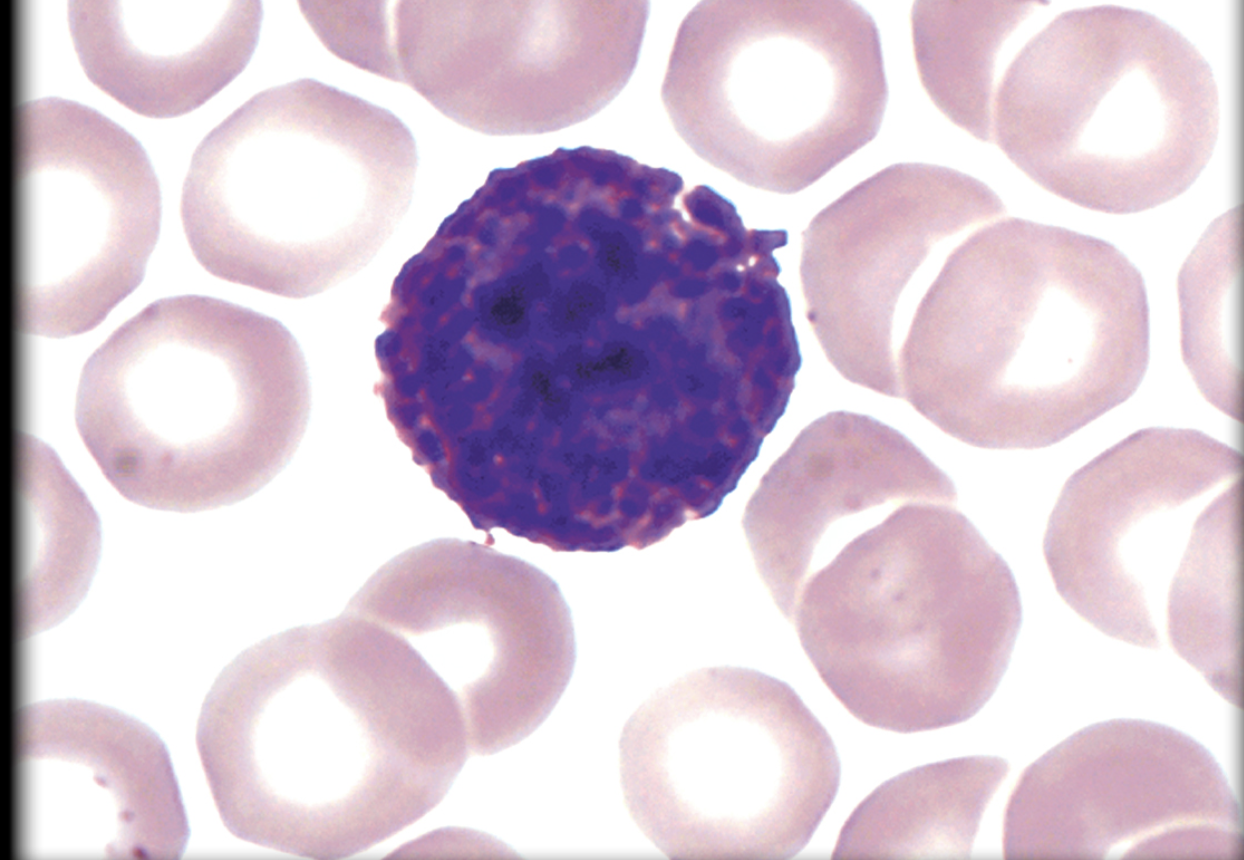
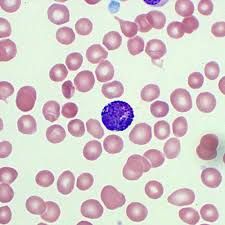
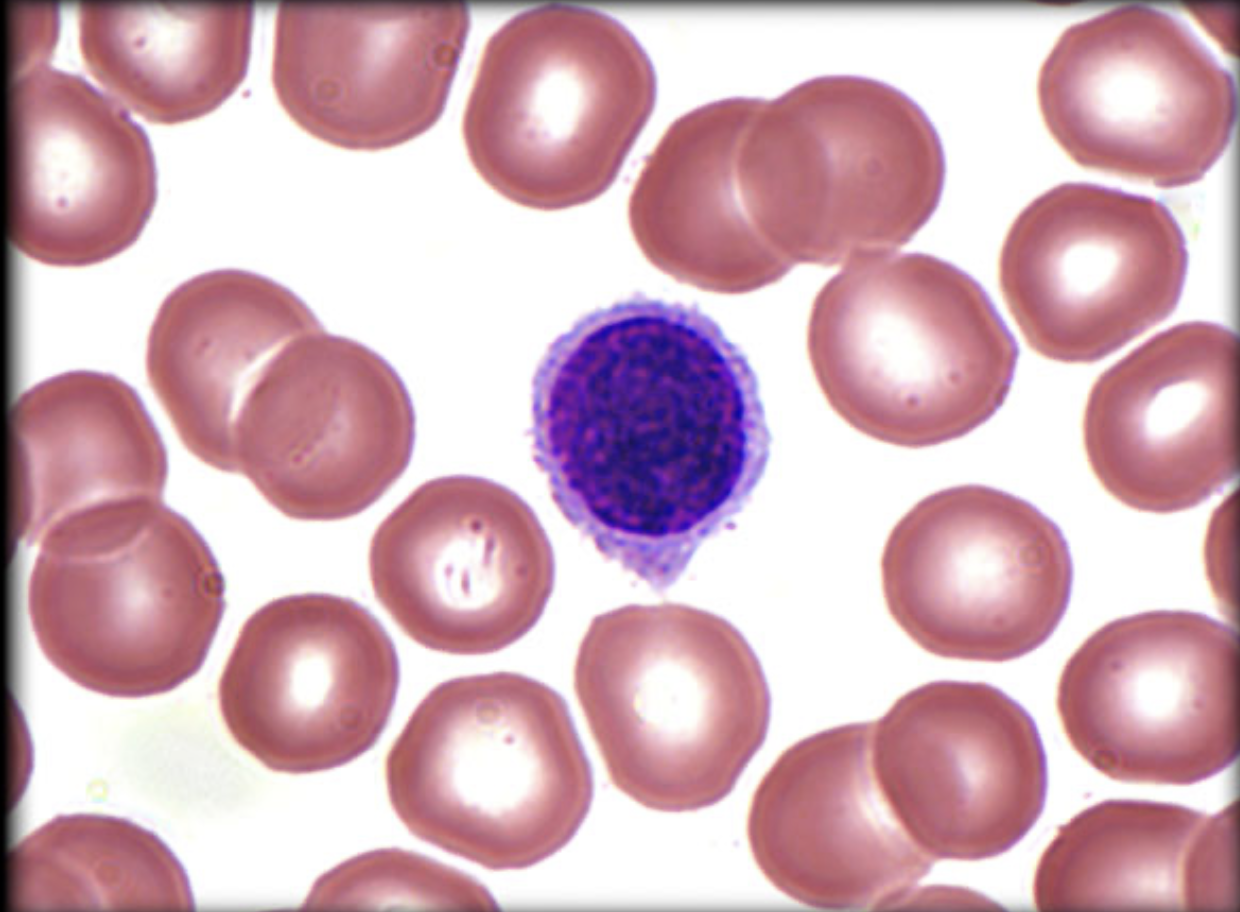
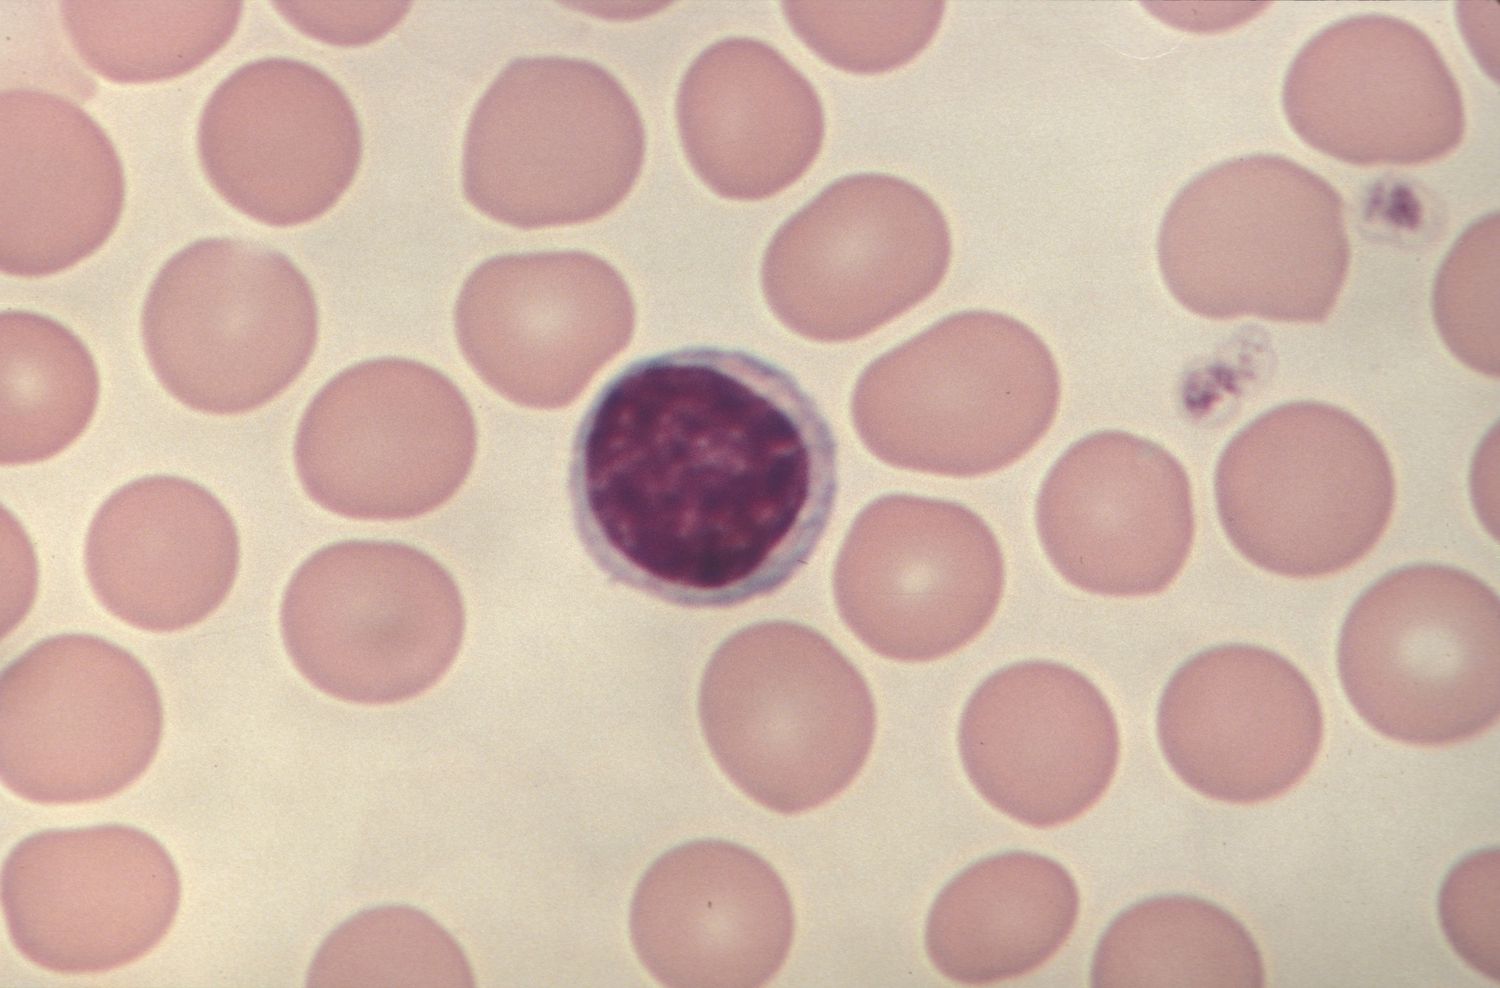
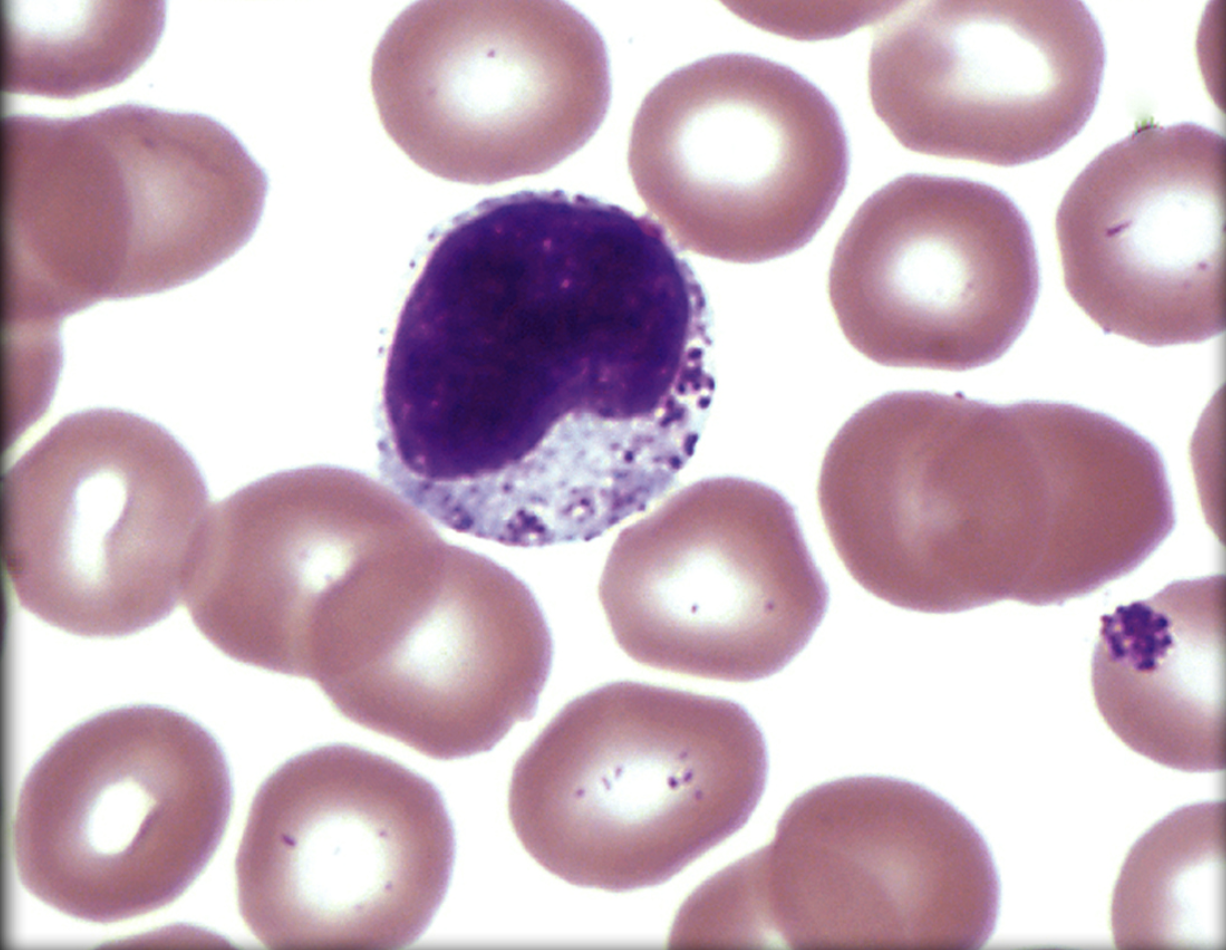

A&P 2 Lab exam #2 (Working?)
1/47
Earn XP
Description and Tags
Name | Mastery | Learn | Test | Matching | Spaced |
|---|
No study sessions yet.
48 Terms

What ducts is the dark green area?
Right lymphatic duct
Deposits in right subclavian vein


What ducts is the light green area?
Thoracic duct
Deposits in Left subclavian vein

Lymph node roles
filter the lymph and remove unwanted substances.
Germinal center: contains lymphocytes, dendritic cells, macrophages, etc to remove pathogens and cancer cells

what concentrated area is this?
Axillary region (lymph nodes)
Axillary nodes

What concentrated area is this?
Cervical region (lymph nodes)
Cervical nodes

What concentrated area is this?
Abdominal region (lymph nodes)
Abdominal nodes

What concentrated area is this?
Inguinal region (lymph nodes)
Inguinal nodes

What is this
Pseudo-stratified ciliated columnar epithelium
Location: Nasal cavity, Trachea, Bronchi, and Bronchioles
Function: Propel debris and mucus to prevent obstructions in airways


What is this
Elastic cartilage
Location: Epiglottis
Function: Directs air and food to appropriate system


What is this
Hyaline cartilage
Location: Nasal cavity, Larynx, Trachea, Bronchi, and Bronchioles
Function: provides physical support to these respiratory structures


What is this
Smooth muscle
Location: Trachea, Bronchi, and Bronchioles
Function: contracts and relaxes to adjust diameter of airways


What is this
Simple squamous epithelium
Location: type I alveoli cells
Function: facilitate gas exchange

What leukocyte is this?
Name: Neutrophil (Granulocyte)
Percent: 50-70%
Function: targets bacteria and fungi
phagocytes
first responders
short life span
☆☆multi-lobed nucleus☆☆

What leukocyte is this?
Name: Eosinophil (Granulocyte)
Percent: 2-4%
Function: targets parasitic worms
live span- several days
☆☆Pretty :)☆☆

What leukocyte is this?
Name: Basophil (Granulocyte)
Percent: <1%
Function: activate other WBCs and parasitic worms
releases histamines (causes inflammation)
plays role in allergies & asthma
live span- several days
☆☆Grainy looking☆☆

What leukocyte is this?
Name: Lymphocyte (Agranulocyte)
Percent: 20-40%
Function: Long time immunity (adaptive immune system)
life span- hours to decades

What leukocyte is this?
Name: Monocyte (Agranulocyte)
Percent: 3-8%
Function: mature into macrophages when activated
life span- several months


Half head model: what structure is this?
Nasal Cavity

Half head model: what structure is this?
Inferior Nasal Conchae

Half head model: what structure is this?
Middle Nasal Conchae

Half head model: what structure is this?
Superior Nasal Conchae

Half head model: what structure is this?
Frontal Sinus

Half head model: what structure is this?
Sphenoidal Sinus

Half head model: what structure is this?
Nasopharynx

Half head model: what structure is this?
Oropharynx

Half head model: what structure is this?
Laryngopharynx

Half head model: what structure is this?
Epiglottis

Half head model: what structure is this?
Larynx (False vocal cords)

Half head model: what structure is this?
Larynx (True vocal cords)

Half head model: what structure is this?
Oral cavity

Larynx, Trachea, and Bronchi model: What structure is this?
Epiglottis

Larynx, Trachea, and Bronchi model: What structure is this?
Larynx (False vocal chords)

Larynx, Trachea, and Bronchi model: What structure is this?
Larynx (True vocal chords)

Larynx, Trachea, and Bronchi model: What structure is this?
Trachea

Larynx, Trachea, and Bronchi model: What structure is this?
Bronchi

Which side of the lung is this?
Right lung (3 lobes)

Which side of the lung is this?
Left lung (2 lobes)

What part of the lungs is this?
Cardiac notch

What cavity is this?
Pulmonary cavity

What cavity is this?
Pleural cavity
Mucous membranes
Location: Line the respiratory tract (e.g., nasal cavity, trachea, bronchi).
Function: Secrete mucus to trap dust, debris, and microbes; moistens and warms incoming air
on organs OPENED to environment
Serous membranes
Location: Surround the lungs and line the thoracic cavity.
Two Layers:
Parietal Pleura: Lines the inside of the thoracic cavity.
Visceral Pleura: Covers the surface of each lung.
Function: Produce pleural fluid to reduce friction during breathing and help the lungs adhere to the chest wall for expansion.
On Organs CLOSE to the environment
Cetirizine
Commercial name: Zyrtec
Purpose: Allergies
Fexofenadine
Commercial name: Allegra
Purpose: Allergies
Loratadine
Commercial name: Claritin
Purpose: Allergies
Diphenhydramine
Commercial name: Benadryl
Purpose: Allergies
Albuterol (salbutamol name)
Commercial name: ProAir / Ventolin
Purpose: Asthma, Bronchitis, and COPD
Prednisone
Commercial name: Deltasone
Purpose: Reduces inflammation & immunosuppressant